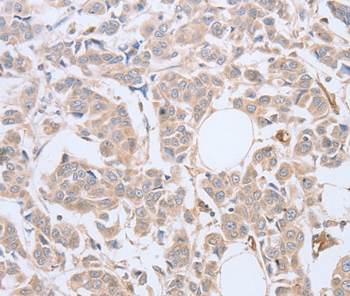

-
分类: 科研抗体货号: P42775别名: NN; NT; NT/N; NTS1; NMN-125应用: WB,IHC反应种属: Human
-
分类: 科研抗体货号: P42794别名: ARP1; CTRN1应用: WB反应种属: Human,Mouse,Rat
-
分类: 科研抗体货号: P42811别名: DEF6; HD-6应用: IHC反应种属: Human
-
分类: 科研抗体货号: P42774别名: MYHa; MYHSA1; MyHC-2x; MyHC-2X/D应用: IHC反应种属: Human
-
分类: 科研抗体货号: P42793别名: ACAD-11应用: WB,IHC反应种属: Human
-
分类: 科研抗体货号: P42810别名: AIO; AIOLOS; ZNFN1A3应用: IHC反应种属: Human
-
分类: 科研抗体货号: P42773别名: HE6WCR54应用: WB反应种属: Human
-
分类: 科研抗体货号: P42792别名: CDS; CGI58; IECN2; NCIE2应用: WB,IHC反应种属: Human
-
分类: 科研抗体货号: P42809别名: PYHIN4应用: IHC反应种属: Human
-
分类: 科研抗体货号: P42791别名: Fz4; EVR1; FEVR; Fz-4; FzE4; GPCR; hFz4; CD344; FZD4S应用: WB,IHC反应种属: Human,Mouse

鄂公网安备42018502007531号
鄂公网安备42018502007531号

